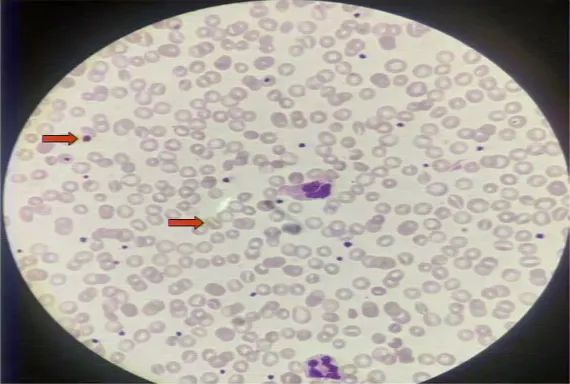
多发性黄色瘤,胆固醇高引起的黄色瘤是什么样的

提到皮肤黄色瘤伴LDL-C浓度大幅升高,大家可能首先想到家族性高胆固醇血症(FH),一种最严重的遗传代谢性疾病。本文介绍一例以皮肤多部位黄色瘤为主要表现,同时伴血脂异常升高的病例。其临床表现酷似FH,但降脂治疗半年后患儿血涂片出现巨大血小板和口形红细胞样变化。是诊断有误还是其他原因?一起来看看。
1 患儿简要病史
患儿,女,5岁,发育正常,饮食结构合理,主诉皮肤多部位黄色瘤4年余,高胆固醇血症6个月。

图1. 患儿多部位黄色瘤。A:手腕手镯样黄色瘤;B:膝盖栗粒样黄色瘤;C:脚腕黄色瘤。
患儿无糖尿病、先天性心血管疾病病史,父母否认高血脂、冠心病、高血压、糖尿病等。
2 辅助检查
血脂检查
总胆固醇:11.59 mmol/L (↑↑);
LDL-C:10.37 mmol/L (↑↑);
甘油三酯:1.24 mmol/L;
HDL-C:0.8 mmol/L。
血常规红细胞:3.58×1012/L;
血红蛋白:101 g/L(↓)。
心肌酶谱、肝肾功能等,均未见异常。
3 诊疗经过
根据2015年美国纯合子FH诊断标准,儿童治疗前LDL-C≥10 mmol/L、10岁前出现皮肤或肌腱黄瘤,即可诊断为纯合子FH。
故患儿诊断为纯合子FH,并给予血脂康两粒bid、依折麦布5 mg/d治疗,同时建议低脂饮食。
6个月后复查,患儿黄色瘤消退(图2)。

图2. A、B、C为治疗前皮肤黄色瘤,D、E、F为治疗后皮肤黄色瘤明显变小。
复查血脂,总胆固醇4.53 mmol/L,LDL-C浓度2.76 mmol/L。心肌酶谱、肝肾功能等均未见明显异常。
血涂片可见巨大血小板和口形红细胞(图3)。
图3. 患儿随访血涂片。
检测患儿父母血脂水平,结果显示正常,不符合显性遗传的规律。因此,“纯合子FH”的诊断是否正确?

图4. 患儿家系图。
对常见的5种FH样表型的致病基因和临床表现进行梳理后,患儿的表现与植物固醇血症极为相似。
表1. 常见FH样表型的致病基因和临床表现

植物固醇血症会是答案吗?使用气相色谱法测定植物固醇,结果表明患儿菜油固醇、豆固醇和谷固醇均异常升高。靶向捕获二代测序显示患儿为纯合突变。
综合以上信息,患儿经饮食控制加药物治疗4个月,LDL-C浓度由10.37 mmol/L降至2.76 mmol/L,血浆植物固醇水平显著升高。基因检测示ABCG8纯合突变,隐性遗传模式。因此,将诊断更正为植物固醇血症。
治疗方面,建议患者进行低植物固醇饮食,给予血脂康两粒bid、依折麦布5 mg/d治疗。
4 讨论
植物固醇血症是一种罕见的常染色体隐性遗传代谢病,由于谷固醇等植物固醇代谢障碍,血清谷固醇、豆固醇等含量异常升高,引起黄色瘤、早发心血管疾病、贫血等病变,其血细胞特点表现为大量口形红细胞和巨大血小板。
治疗方面,提倡使用依折麦布进行治疗,可通过饮食控制,严格限制食物中胆固醇和谷固醇的含量。
发病机制
正常情况下,植物固醇在小肠固醇内转运子NPC1L1的作用下被吸收,过量的植物固醇则在固醇外转运子ABCG5和ABCG8作用下主动排出。由于ABCG5或ABCG8基因突变导致谷固醇、豆固醇蓄积,无法排出,吸收量升高至正常的50~200倍。

图5. 植物固醇血症发病机制。
植物固醇血症有致动脉粥样硬化性
2019年荷兰马斯特里赫特大学学者发表系统综述指出,多数研究表明植物固醇升高具有致动脉粥样硬化性,是体内胆固醇稳态失衡的信号。植物固醇致动脉粥样硬化的危险性大于胆固醇,表现在以下几个方面。
① 直接毒性
• 渗入细胞膜:植物固醇渗入细胞膜后会造成膜流动性下降,通透性降低,引起脂代谢障碍;•极易氧化:损伤内皮,促进巨噬细胞泡沫化,加速其死亡;•形成易损斑块:促进血栓形成,引起急性心梗和猝死;•渗入血小板膜:导致血小板过度活化,增加出血倾向。② 间接作用:改变胆固醇稳态。鉴别诊断
植物固醇血症的临床表现与FH十分相似,应注意鉴别诊断,通过血清植物固醇谱和基因分析可确诊。
表2. FH和植物固醇血症的鉴别诊断

来源
王绿娅. 从误诊病例认识植物固醇血症. 长城会2019.